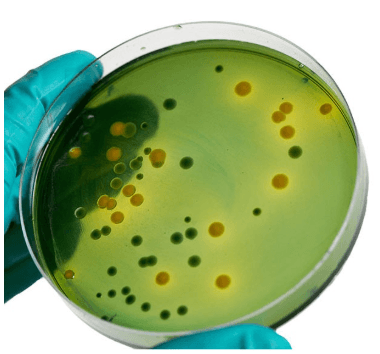
Resistencia antimicrobiana en Salmonella spp.: análisis fenotípico, genotípico y perspectivas desde el enfoque de Una Salud - Image 1

Introducción
La Resistencia Antimicrobiana (RAM) representa uno de los mayores desafíos en la salud pública global, comprometiendo la eficacia de los tratamientos antibióticos y generando un impacto significativo en la medicina humana y veterinaria. Este fenómeno, mediado por elementos genéticos móviles como plásmidos, transposones e integrones, facilita la diseminación de genes de resistencia entre bacterias mediante transferencia horizontal, sin necesidad de replicación bacteriana y contribuye significativamente al fracaso terapéutico en infecciones (Fišarová et al., 2019).
El uso intensivo de antibióticos en medicina humana y veterinaria ha sido identificado como un factor clave en el desarrollo y diseminación de la RAM. En Colombia, estudios realizados en granjas avícolas ubicadas en Cundinamarca y Santander han reportado tasas de resistencia en Salmonella spp., incluyendo un 98% a ceftiofur, 95% a tetraciclina y 76% a estreptomicina (Donado-Godoy et al., 2012). Estos resultados son consistentes con los datos de vigilancia del Instituto Nacional de Salud (INS), que entre 2014 y 2018, identificó resistencia elevada a ampicilina, cefotaxima, cloranfenicol y trimetoprima/sulfametoxazol en serovares como S. Typhimurium y S. Enteritidis (INS, 2019). Asimismo, investigaciones en países como Brasil, Perú y Estados Unidos han reportado hallazgos similares en productos de origen avícola, con alta resistencia a tetraciclina, ampicilina y ácido nalidíxico (Velasquez et al., 2018).
El medio ambiente también actúa como un reservorio de genes RAM, particularmente en ecosistemas impactados por actividades pecuarias. Estudios han demostrado la presencia de genes como floR, qnrS, blaTEM y sul2 en aguas y suelos cercanos a granjas avícolas, resaltando su rol en la diseminación de resistencia a lo largo de la cadena (Riesenfeld et al., 2004). Adicionalmente, la identificación del integrón de clase 1, un vehículo clave en la diseminación de genes RAM, resalta la relevancia de los elementos móviles en este proceso. La prevalencia del integrón de clase 1 ha sido reportada entre el 40 y el 50% en bacterias Gram negativas, incluida Salmonella spp. (Pormohammad et al., 2019).

La RAM a fluoroquinolonas y cefalosporinas en Salmonella spp. también es considerada prioritaria por la OMS debido a su impacto en infecciones humanas graves. Este problema refleja el uso excesivo de estos antibióticos en producciones pecuarias, subrayando la necesidad de generar estrategias globales para limitar la diseminación de RAM. La identificación de genes emergentes como mcr-1, asociado a resistencia a colistina, refuerza esta preocupación y destaca la importancia de una gestión responsable del uso de antibióticos y desinfectantes desde el enfoque de Una Salud (INS, 2019; OMSA, 2022) (Figura 1).
Materiales y métodos
En este estudio se analizaron 50 aislamientos de Salmonella spp. obtenidos entre 2008 y 2021 del banco de cepas del Laboratorio de Patología Aviar (LPA) de la Facultad de Medicina Veterinaria y de Zootecnia de la Universidad Nacional de Colombia, procedentes de granjas avícolas de diferentes departamentos del país. Las cepas fueron reactivadas en agar Tripticasa de Soya (TSA) e incubadas a 37 °C por 24 h, confirmándose su morfología de bacilos Gram negativos mediante tinción de Gram.
La extracción del ADN genómico se realizó a partir de suspensiones equivalentes a 2×10⁹ UFC empleando el kit PureLink™ Genomic DNA Mini Kit (Thermo Fisher Scientific), siguiendo las recomendaciones del fabricante. La concentración y pureza del ADN se evaluaron por espectrofotometría (NanoDrop) a 260/280 nm. La confirmación molecular del género Salmonella se efectuó mediante amplificación por PCR de los genes 16S rRNA (1500 pb) e invA (284 pb). Para la identificación del serovar, se amplificó y secuenció la región intergénica ISR (≈1400 pb), localizada entre los genes 23S rRNA y aspU-dkgB, cuyos productos fueron analizados mediante electroforesis en gel al 1.5 %, purificados y secuenciados en el Instituto de Genética de la Universidad Nacional de Colombia. Las secuencias fueron comparadas mediante BLAST con la base de datos del NCBI para determinar el serotipo correspondiente.
La susceptibilidad antimicrobiana se evaluó por el método de Kirby-Bauer según las normas del Clinical and Laboratory Standards Institute (CLSI), utilizando una batería de antibióticos representativos de diferentes familias (Tabla 1). Los aislamientos resistentes a tres o más grupos antimicrobianos se clasificaron como multirresistentes (MRS).
A partir del ADN extraído se realizaron PCR específicas para detectar 21 genes de resistencia a β-lactámicos, cefalosporinas, sulfonamidas, quinolonas/fluoroquinolonas, fenicoles y aminoglucósidos, además de los genes asociados a resistencia a desinfectantes (qacE y sugE(p)) y al elemento integrón, implicado en la adquisición y transferencia de genes RAM (Tabla 1) (Figura 2).
Figura 1. Genes y Resistencia Antimicrobiana (RAM) en bacterias. La RAM es mediada por genes que se pueden transmitir entre humanos, animales y ambiente, siendo un problema que se debe abordar desde el enfoque de Una Salud.Resultados y discusión
Se identificaron 12 serotipos de Salmonella, distribuidos de la siguiente manera: S. Gallinarum (n=12, 24%), S. Heidelberg (n=10, 20%), S. Enteritidis (n=9, 18%), S. Thompson (n=4, 8%), S. Mbandaka (n=4, 8%), S. Infantis (n=3, 6%), S. Javiana (n=3, 6%), S. Saintpaul (n=1, 2%), S. Stanleyville (n=1, 2%), S. Tennessee (n=1, 2%), S. Agona (n=1, 2%) y S. Paratyphi B (n=1, 2%). La identificación precisa de los serotipos de Salmonella es esencial porque existen diferencias en su patogenicidad para aves y humanos y debido al gran número de serovares descritos (Shah et al., 2017). La presencia de portadores asintomáticos en granjas y la persistencia ambiental del patógeno dificultan la detección temprana, favoreciendo su diseminación a lo largo de la cadena alimentaria (Carey et al., 2023). Si bien las metodologías tradicionales como el cultivo y la serotipificación son útiles, su ejecución exige tiempo y recursos, retrasando la toma de decisiones. Por ello, las metodologías moleculares se han consolidado como alternativas para el diagnóstico de laboratorio (Aydin et al., 2018). En este estudio se seleccionaron tres genes de identificación: 16S rRNA, invA e ISR, con el fin de reconocer el género y discriminar entre serovares. El gen 16S rRNA, por su alta conservación, permitió confirmar la presencia de bacterias en todos los aislamientos, pero su capacidad discriminativa no permite separar serovares de Salmonella (Woese, 1987). Por ello se incorporó el gen invA, el cual codifica una proteína esencial para la invasión celular y se considera altamente específico para el género Salmonella (Heran et al., 1999; Malorny et al., 2003; Mohammed, 2024; Rahn,’ et al., 1992). Finalmente, la región ISR —localizada entre rrlH (23S), aspU (tRNA-Asp) y dkgB— permitió diferenciar los serovares analizados mediante el análisis de polimorfismos (Guard et al., 2023), tal como lo han mostrado estudios previos con porcentajes elevados de amplificación y concordancia en la tipificación (Pulido-Landínez et al., 2013, 2014). La combinación de estos tres marcadores posibilitó la diferenciación de la totalidad de los aislamientos incluidos en esta investigación.
Figura 2. Representación esquemática de la metodología del estudio. La investigación incluyó 50 aislamientos de Salmonella spp. del Banco del Laboratorio de Patología Aviar de la Universidad Nacional de Colombia. Se realizaron pruebas de genotipo y fenotipo para evaluar la resistencia antimicrobiana.
Tabla 1. Familias de antibióticos, sus respectivos antibióticos y genes asociados incluidos en la investigación.En cuanto al origen de los aislamientos, el 68% (n=34) se obtuvo de muestras provenientes de aves, las cuales incluyeron órganos (hígado, vesícula biliar, bazo y folículos ováricos) e hisopos cloacales. Las muestras también incluyeron médula ósea de la mortalidad de las granjas. El 22% (n=11) correspondió a muestras ambientales, recolectadas de superficies como ropa de trabajadores, pisos de granjas, materia prima para alimento, máquinas clasificadoras de huevos, incubadoras y agua tratada de tanques. El 10% (n=5) correspondió a aislamientos de productos destinados al consumo humano, como huevos, pasta de pollo y canales de pollo. Las detecciones de Salmonella spp. en muestras ambientales subrayan la importancia de reforzar las medidas de bioseguridad en las granjas. El agua y las superficies pueden facilitar la propagación de la bacteria, lo que resalta la necesidad de un monitoreo continuo para reducir el riesgo de contaminación cruzada y proteger a los consumidores de posibles casos de gastroenteritis (Carey et al., 2023; Jiang et al., 2023; Shaji et al., 2023).
En los 50 aislamientos analizados, se observaron patrones diferenciados de RAM, destacándose los altos porcentajes de resistencia frente a tilmicosina (100%), estreptomicina (80%), cefoxitina (70%) y ácido nalidíxico (64%). Estas cifras podrían reflejar la presión selectiva generada por el uso frecuente de algunos de estos antimicrobianos en la producción avícola o de otras moléculas pertenecientes a la misma familia, posicionando a Salmonella spp. como un reservorio de resistencia múltiple (Nowakiewicz et al., 2020). Por otro lado, ninguno de los aislamientos presentó resistencia frente a levofloxacina, lo que sugiere una eficacia conservada de este antibiótico frente a Salmonella spp. y subraya la necesidad de uso prudente para prevenir el desarrollo de resistencia. Este análisis de RAM reveló niveles de resistencia a antibióticos de importancia para la salud pública.
La resistencia observada frente a tilmicosina en este estudio no se debe a la adquisición de genes de resistencia, sino a una resistencia intrínseca común en bacterias gram negativas como Salmonella spp. Este patrón está asociado a barreras estructurales en la membrana celular que limitan la penetración de macrólidos, además de sistemas de eflujo que eliminan activamente estos compuestos. Lo anterior, puede ejercer presión selectiva indirecta sobre otros grupos de antibióticos, favoreciendo la proliferación de bacterias resistentes que comparten nichos ecológicos con Salmonella.
S. Infantis se destacó como el serovar con mayor RAM, mostrando resistencia a casi todos los antibióticos evaluados. Otros serovares, como S. Javiana, S. Mbandaka y S. Thompson, exhibieron patrones variables de resistencia frente a los antibióticos estudiados, reflejando heterogeneidad en los perfiles fenotípicos observados. Entre los serovares con el mayor número de aislamientos, S. Gallinarum presentó el perfil de resistencia más bajo (Tabla 2). Los resultados de S. Infantis refuerzan su potencial para diseminar genes de resistencia mediante elementos genéticos móviles. En contraste, S. Gallinarum, aunque fue el serovar más frecuente, mostró un perfil de resistencia relativamente bajo, posiblemente debido a su carácter no zoonótico y las prácticas específicas de manejo en granjas (Zishiri et al., 2016). Este perfil de resistencia más bajo podría reflejar diferencias en el uso de antibióticos o en las características intrínsecas de este serovar que limitan el desarrollo de resistencia. Sin embargo, es importante considerar que los aislamientos incluidos en este estudio corresponden a casos históricos del Laboratorio de Patología Aviar y no a seguimientos epidemiológicos de rutina en granjas avícolas. Esto resalta la necesidad de ampliar el alcance de los estudios a las diferentes regiones productoras en Colombia, considerando factores locales como prácticas de bioseguridad, manejo de granjas y uso de antimicrobianos.
El 82% (n=41) de los serovares de Salmonella spp. identificados en este estudio presentaron un perfil multirresistente (MRS), es decir, resistencia a tres o más grupos de antibióticos. De estos, 28 aislamientos correspondieron a muestras provenientes de aves (28/34), ocho a muestras ambientales (8/11)) y cinco a muestras de productos para consumo humano (5/5). Por otro lado, el 18% restante (n=9) mostró resistencia a uno o dos grupos de antibióticos, lo que no se considera un fenotipo multirresistente; de éstos, seis se aislaron de aves y tres de muestras ambientales. Desde una perspectiva clínica, la resistencia múltiple observada en este trabajo limita las opciones terapéuticas, especialmente en casos de salmonelosis, donde las quinolonas y cefalosporinas de tercera generación son fundamentales. Además, S. Infantis y S. Heidelberg presentaron perfiles preocupantes de resistencia simultánea a betalactámicos, quinolonas y tetraciclinas. Esta tendencia, consistente con estudios internacionales, resalta la capacidad de estos serovares para adquirir y diseminar genes de resistencia mediante plásmidos y transposones, exacerbando el problema global de la RAM (Carson et al., 2019).
El impacto ambiental del uso de antimicrobianos en sistemas pecuarios se refleja en los niveles de RAM observados en aislamientos ambientales. Es importante destacar que en el aumento de la RAM intervienen diversos factores asociados con las industrias pecuarias e incluso con el sector de salud humana. Los residuos de antibióticos liberados a través de las heces a los suelos y aguas residuales no solo actúan como contaminantes persistentes, sino que también favorecen la selección y propagación de bacterias resistentes en el ecosistema (Manyi-Loh et al., 2018). Otro hallazgo que llama la atención en el estudio es que el 82% de los aislamientos de Salmonella spp. presentaron perfiles MRS, definidos como resistencia a tres o más clases de antimicrobianos. Este hallazgo refuerza el papel de Salmonella como un reservorio clave de RAM en sistemas de producción (Castro-Vargas et al., 2020).
Este nivel de multirresistencia observado en este estudio y en investigaciones realizadas alrededor del mundo refuerza la necesidad de enfoques integrados basados en el concepto de Una Salud. Esto incluye la vigilancia continua de RAM en los sistemas de producción, la regulación estricta del uso de antimicrobianos y la implementación de estrategias de manejo sostenible que reduzcan la presión selectiva en la microbiota aviar. Los resultados aquí reportados, particularmente la resistencia múltiple en serovares como S. Infantis y S. Heidelberg, destacan su relevancia como vectores de resistencia en la cadena alimentaria, con implicaciones para la salud pública.
En los 50 aislamientos analizados, se identificaron patrones diferenciados en la detección de genes asociados a RAM. De los 22 genes evaluados, 15 fueron detectados en al menos una de las muestras. El qepA mostró una detección del 100%, seguido por blaTEM-1 (76%) y dhfr1 (74%). En contraste, los demás genes detectados presentaron porcentajes menores al 50% (Figura 3). Por otro lado, siete genes no se detectaron en ninguna de las muestras analizadas. Entre estos se encuentran blaPSE-1, blaCTX-M, aadA2, aadB, grm, mcr-1 y qacE(p) (gen que otorga resistencia a desinfectantes) (Figura 3). El gen blaTEM-1, presente en el 76% de los aislamientos, reafirma su papel predominante en la resistencia a betalactámicos en Salmonella spp., un hallazgo consistente con estudios realizados en otros países (Di Francesco et al., 2021; Wilson et al., 2019).
En los 50 aislamientos analizados, se identificaron patrones diferenciados en la detección de genes asociados a RAM. De los 22 genes evaluados, 15 fueron detectados en al menos una de las muestras. El qepA mostró una detección del 100%, seguido por blaTEM-1 (76%) y dhfr1 (74%). En contraste, los demás genes detectados presentaron porcentajes menores al 50% (Figura 3). Por otro lado, siete genes no se detectaron en ninguna de las muestras analizadas. Entre estos se encuentran blaPSE-1, blaCTX-M, aadA2, aadB, grm, mcr-1 y qacE(p) (gen que otorga resistencia a desinfectantes) (Figura 3). El gen blaTEM-1, presente en el 76% de los aislamientos, reafirma su papel predominante en la resistencia a betalactámicos en Salmonella spp., un hallazgo consistente con estudios realizados en otros países (Di Francesco et al., 2021; Wilson et al., 2019).
Los serovares S. Enteritidis y S. Heidelberg presentaron la mayor cantidad de genes de resistencia (14 de 22), posicionándolos como los serovares con mayor diversidad genética relacionada con RAM. En contraste, S. Stanleyville fue el serovar con menor detección de genes RAM, con solo cuatro de 22 genes identificados. Este contraste subraya la importancia de realizar estudios adicionales que exploren los factores ambientales, productivos y epidemiológicos que influyen en la diversidad genética de este patógeno, especialmente en regiones y entornos con prácticas avícolas. Estos hallazgos refuerzan la relevancia de integrar la diversidad genética como un componente clave en las estrategias de vigilancia y control de RAM (Abukhattab et al., 2022).
En S. Agona, S. Paratyphi B, S. Saintpaul, S. Stanleyville y S. Tennessee, todos los genes detectados presentaron tasas del 100%. Por otro lado, S. Thompson mostró un perfil más heterogéneo, con tasas de detección variadas, aunque en general superiores al 50%. En los demás serovares, los porcentajes de detección fueron variables. Es importante resaltar que cinco serovares (S. Agona, S. Enteritidis, S. Heidelberg, S. Paratyphi B y S. Saintpaul), presentaron porcentajes de resistencia al gen sugE(p) que otorga resistencia a desinfectantes.
En cuanto a genes relacionados con resistencia a trimetoprima, dhfr1 y dfrA1, mostraron tasas de detección del 74 y 32%, respectivamente, sugiriendo que el uso frecuente de este antimicrobiano puede contribuir a este hallazgo. Además, genes relacionados con resistencia a desinfectantes, como sugE(p), fueron detectados en el 20% de los aislamientos, pero no se evaluaron los fenotipos de resistencia a estos compuestos, lo que limita las conclusiones sobre su impacto real (Zou et al., 2014).

Click aquí para ampliar la imagen Figura 3. Porcentaje de detección de genes mediadores de los mecanismos de resistencia antimicrobiana (RAM) en los aislamientos de Salmonella spp. incluidos en el estudio
Un hallazgo significativo fue la detección de integrones, elementos genéticos móviles clave en la diseminación de genes RAM. Estos resultados coinciden con estudios internacionales que destacan la relevancia de integrones de clase 1 como reservorios de resistencia (Abukhattab et al., 2022). Aunque su prevalencia fue baja, su impacto como facilitadores de transferencia horizontal subraya la importancia de implementar estrategias de manejo de residuos para mitigar la propagación de resistencia en el ambiente.
Click aquí para ampliar la imagen Tabla 2. Porcentajes de resistencia a los antibióticos en diferentes serovares de Salmonella spp., incluyendo el número de aislamientos por serovar. Los valores se representan mediante un esquema de colores, donde los tonos más oscuros indican un mayor porcentaje de resistencia.AMP: Ampicilina, SAM: Ampicilina sulbactam, AMC: Ácido clavulánico amoxicilina, KF: Cefalotina, CAZ: Ceftazidima, EFT: Ceftiofur, FOX: Cefoxitina, CRO: Ceftriaxona, CTX: Cefotaxima, FEP: Cefepime, CN: Gentamicina, S: Estreptomicina, K: Kanamicina, TE: tetraciclina, OT: Oxitetraciclina, TIL: Tilmicosina, FFC: Florfenicol, NA: Ácido nalidíxico, ENR: enrofloxacina, LEV: Levofloxacina, SXT: trimetoprima/sulfametoxazol.
Finalmente, factores como la pérdida del fenotipo de resistencia en ausencia de presión selectiva o la falta de expresión de genes RAM debido a regulación negativa o mutaciones en promotores destacan la complejidad inherente de la RAM. Estas dinámicas destacan la importancia de integrar análisis funcionales que incluyan expresión génica y mecanismos cromosómicos para una comprensión más integral del fenómeno (Bell et al., 2015).
En conclusión, este estudio refuerza la utilidad del análisis genotípico para comprender y predecir patrones de resistencia fenotípica en Salmonella spp.. Las limitaciones metodológicas, como la falta de detección de ciertos genes clave y la baja variabilidad de otros, resaltan la necesidad de ampliar las herramientas analíticas e incorporar técnicas avanzadas que incluyan mutaciones cromosómicas y análisis funcionales para capturar mejor la dinámica de RAM. La identificación de integrones, aunque limitada, reafirma su importancia como reservorios genéticos en la diseminación de genes de resistencia, destacando la necesidad de mitigar su propagación en sistemas productivos.
Los hallazgos de este trabajo resaltan la importancia de implementar estrategias integrales que incluyan sistemas de vigilancia genómica y enfoques multidisciplinarios. La integración de análisis genotípicos y fenotípicos avanzados, junto con políticas de regulación del uso de antimicrobianos y buenas prácticas de manejo, aportará de manera efectiva a enfrentar el desafío global de la RAM y proteger la salud pública en el marco del enfoque de Una Salud.
Agradecimientos
Este trabajo fue posible gracias al apoyo institucional y financiero de la Asociación Colombiana de Médicos Veterinarios y Zootecnistas Especialistas en Avicultura (AMEVEA) mediante el Fondo de Apoyo a la Investigación Dr. Pedro Villegas Narváez – 2023. Las autoras reconocen y valoran su constante compromiso con la promoción de la investigación científica en beneficio de la avicultura colombiana.